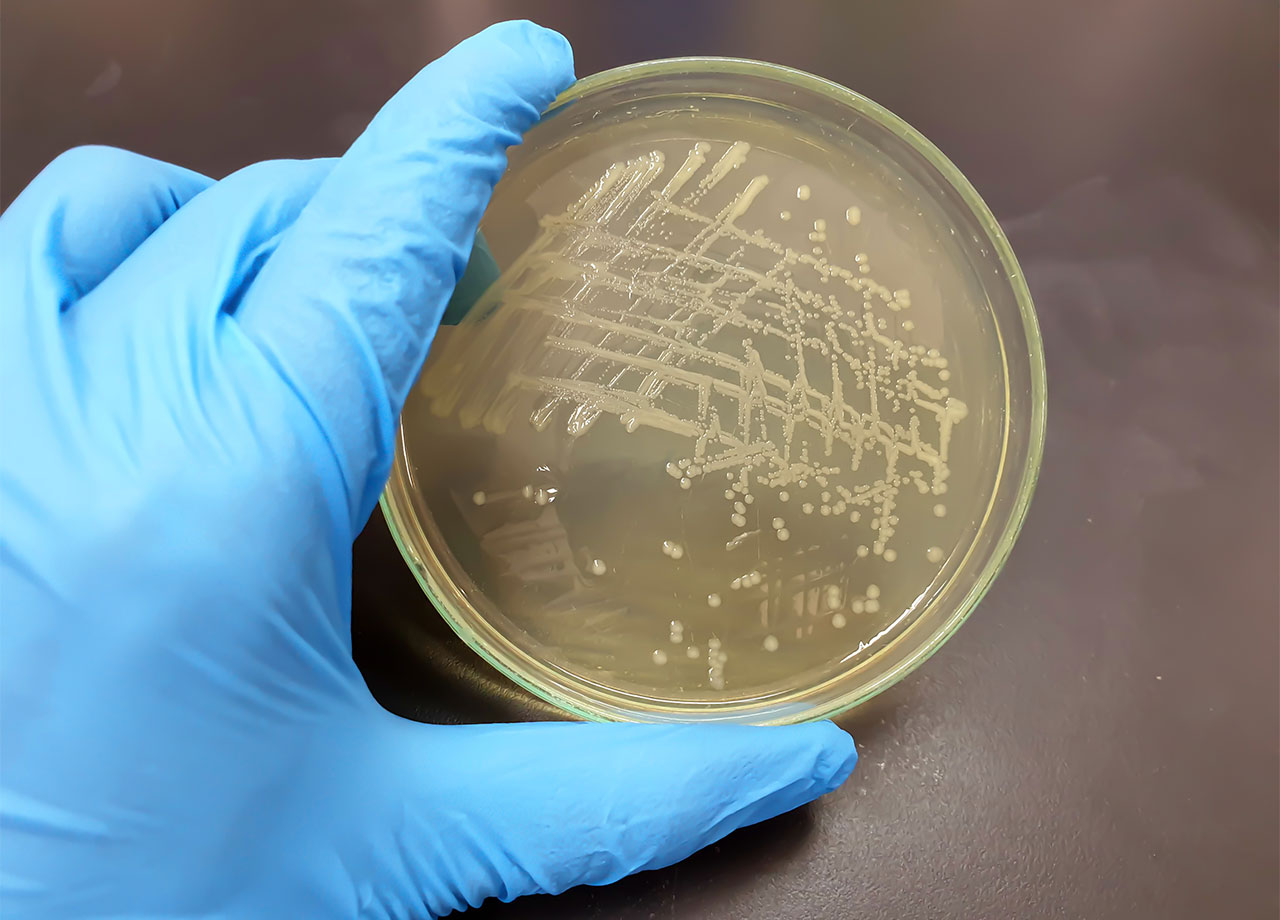

Fresh basil from Trader Joe’s across 29 states has been pulled from shelves after a salmonella outbreak that affected 12 different individuals in 7 different states. The US Food and Drug Administration (FDA) reported the recall, which was initiated voluntarily by Infinite Herbs, the manufacturer, on April 17, 2024.Read on for more details, including exactly which products the recall includes and what to do if you’ve purchased them.


Basil Recall
The affected basil from Infinite Herbs is sold fresh and packaged in a 2.5-ounce clear plastic clamshell container. It was sold in 29 states, including Alabama, Connecticut, Delaware, Florida, Georgia, Iowa, Illinois, Indiana, Kansas, Kentucky, Massachusetts, Maryland, Maine, Michigan, Minnesota, Missouri, North Carolina, Nebraska, New Hampshire, New Jersey, New York, Ohio, Pennsylvania, Rhode Island, South Carolina, Tennessee, Virginia, Vermont and Wisconsin.
The UPC Code, which can be found on the packaging, is 8 18042 02147 7, and the product was sold between February 1 and April 6. While the product has likely gone bad by now, consumers are encouraged to check their fridges and freezers just to be safe.
Salmonella Contamination
The recall was initiated after 12 illnesses directly related to the consumption of the Infinite Herbs basil were reported. Of these 12 reports, there was one hospitalization, with the last illness onset occurring on April 2. The illnesses were reported in Florida, Georgia, Minnesota, Missouri, New Jersey, Rhode Island and Wisconsin.
Symptoms of Salmonella illness usually occur within 12 to 72 hours after consuming a contaminated product and can unfortunately stick around for up to a week. Symptoms may include diarrhea, fever and abdominal cramps. Children under the age of 5, the elderly and people with weakened immune systems are more likely to have severe infections.

What To Do If You've Purchased The Recalled Basil
If you have purchased basil from Trader Joe's with the Infinite Herbs, stop consumption immediately. If you are experiencing any of the above symptoms, you should contact your healthcare provider. Even if you're just using the basil for garnish or as a flavoring for a beverage (ie: not directly consuming the product), you are still running the risk of Salmonella infection. It's better to be safe than sorry!


























